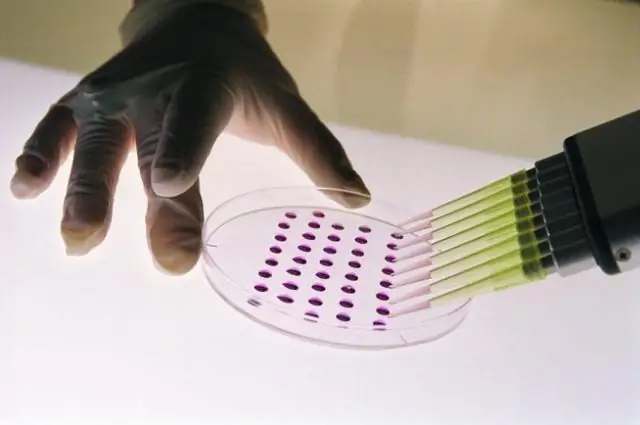
Раскрыта молекулярная основа основного механизма передачи устойчивости к антибиотикам

Одной из самых больших текущих угроз для глобального здравоохранения является рост числа бактерий с множественной лекарственной устойчивостью, вызванный распространением среди них устойчивости к антибиотикам. Пытаясь помочь в борьбе с этой угрозой, исследователи EMBL раскрыли молекулярную основу основного механизма передачи устойчивости к антибиотикам. Они также разработали молекулы и доказательство принципа блокировки этой передачи. Cell опубликует свои результаты 15 марта.
Бактерии выработали устойчивость к большинству лекарственных соединений, которые мы используем сегодня. Примеры бактерий с множественной лекарственной устойчивостью включают организмы, которые являются частью нашего нормального микробиома и поэтому трудно поддаются искоренению, такие как MRSA (метициллин-резистентный золотистый стафилококк), VRE (ванкомицин-резистентный энтерококк) и ESBL (бета-лактамаза расширенного спектра). продуцирующие Enterobacteriaceae.
Прыгающая ДНК: средство распространения сопротивления
Одной из основных движущих сил распространения резистентности между бактериями являются транспозоны, также называемые прыгающей ДНК: генетические элементы, которые могут автономно менять местоположение в геноме. При переносе между бактериями транспозоны могут нести внутри себя гены устойчивости к антибиотикам.
Исследования группы Barabas в EMBL сосредоточены на транспозонах и их молекулярной структуре. Теперь команда представила первую кристаллическую структуру белково-ДНК-машины, которая вставляет транспозоны, включая резистентность, которую они несут, в бактерии-реципиенты.
Исследовательская группа обнаружила, что рабочая лошадка машины для введения транспозонов, белок транспозаза, имеет необычную форму (СМ. ИЗОБРАЖЕНИЕ). Это позволяет ему связываться с ДНК в неактивном состоянии, что предотвращает расщепление и, таким образом, разрушение транспозона до тех пор, пока он не сможет вставить ген устойчивости к антибиотикам в геном нового хозяина. Особая форма белка также заставляет ДНК транспозона раскручиваться и открываться, что позволяет ему вставлять свой груз устойчивости к антибиотикам во многих местах в самых разных бактериях.
"Если вы думаете о веревках или проводах, они обычно связаны и смотаны, чтобы сделать их более прочными. Если вы хотите порвать или разрезать один из них, будет намного проще, если вы сначала размотаете и ослабите его", - говорит EMBL. руководитель группы Орсоля Барабас, руководившая работами. «То же самое и с ДНК, и механизм переноса транспозонов использует это преимущество». Белок транспозаза сначала раскручивает и разделяет нити ДНК транспозона, что облегчает их вырезание и вставку в новое место в геноме реципиента.
Стратегии ограничения распространения резистентности
Основываясь на кристаллической структуре, Барабас и ее коллеги также разработали молекулы и предоставили доказательство принципа блокировки движения транспозонов.«В долгосрочной перспективе это может помочь контролировать распространение генов устойчивости к антибиотикам», - говорит она. Они предлагают две стратегии блокирования передачи, которые могут, например, предотвратить передачу резистентности у людей, у которых диагностированы носители устойчивых к антибиотикам бактерий.
Первый препятствует переходу белка транспозазы в активированную конформацию, блокируя его архитектуру новым пептидом, короткой цепью аминокислот.
Второй метод представляет собой ДНК-имитатор, который связывается с открытым сайтом внутри транспозона, таким образом блокируя замену цепи ДНК, которая необходима для передачи резистентности. Барабас: «Поскольку мы считаем, что эти особенности широко представлены в этих прыгающих элементах ДНК, но не в родственных клеточных системах, они могут быть весьма специфичны для транспозонов. Таким образом, мы можем нацеливаться только на нужные нам бактерии, а не на множество хороших бактерий. в наших телах и окружающей среде."
До сих пор предстоит пройти долгий путь между демонстрацией молекулярной структуры механизмов передачи резистентности in vitro и будущими приложениями. Вот почему Барабас и его коллеги теперь сосредоточатся на лучшем понимании механизмов передачи в реальной жизни, а также на тестировании и дальнейшей разработке стратегий ограничения передачи. Они сотрудничают с исследовательскими группами по всему миру, изучая их как в лаборатории, так и в клинике.